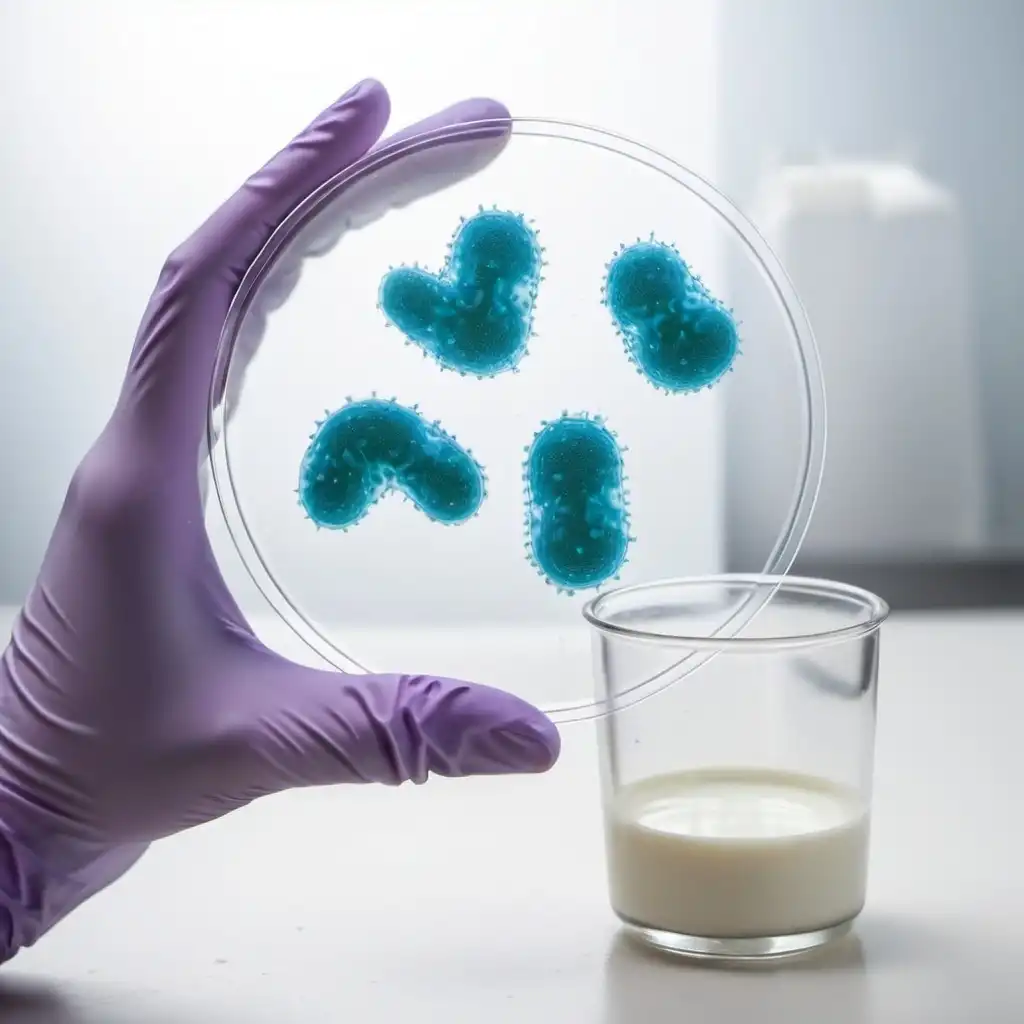

图片提示词prompt
ragazzo che fluttua nello spazio che guarda la terra
拉加佐·长笛手、内洛·斯帕齐奥·大地卫士